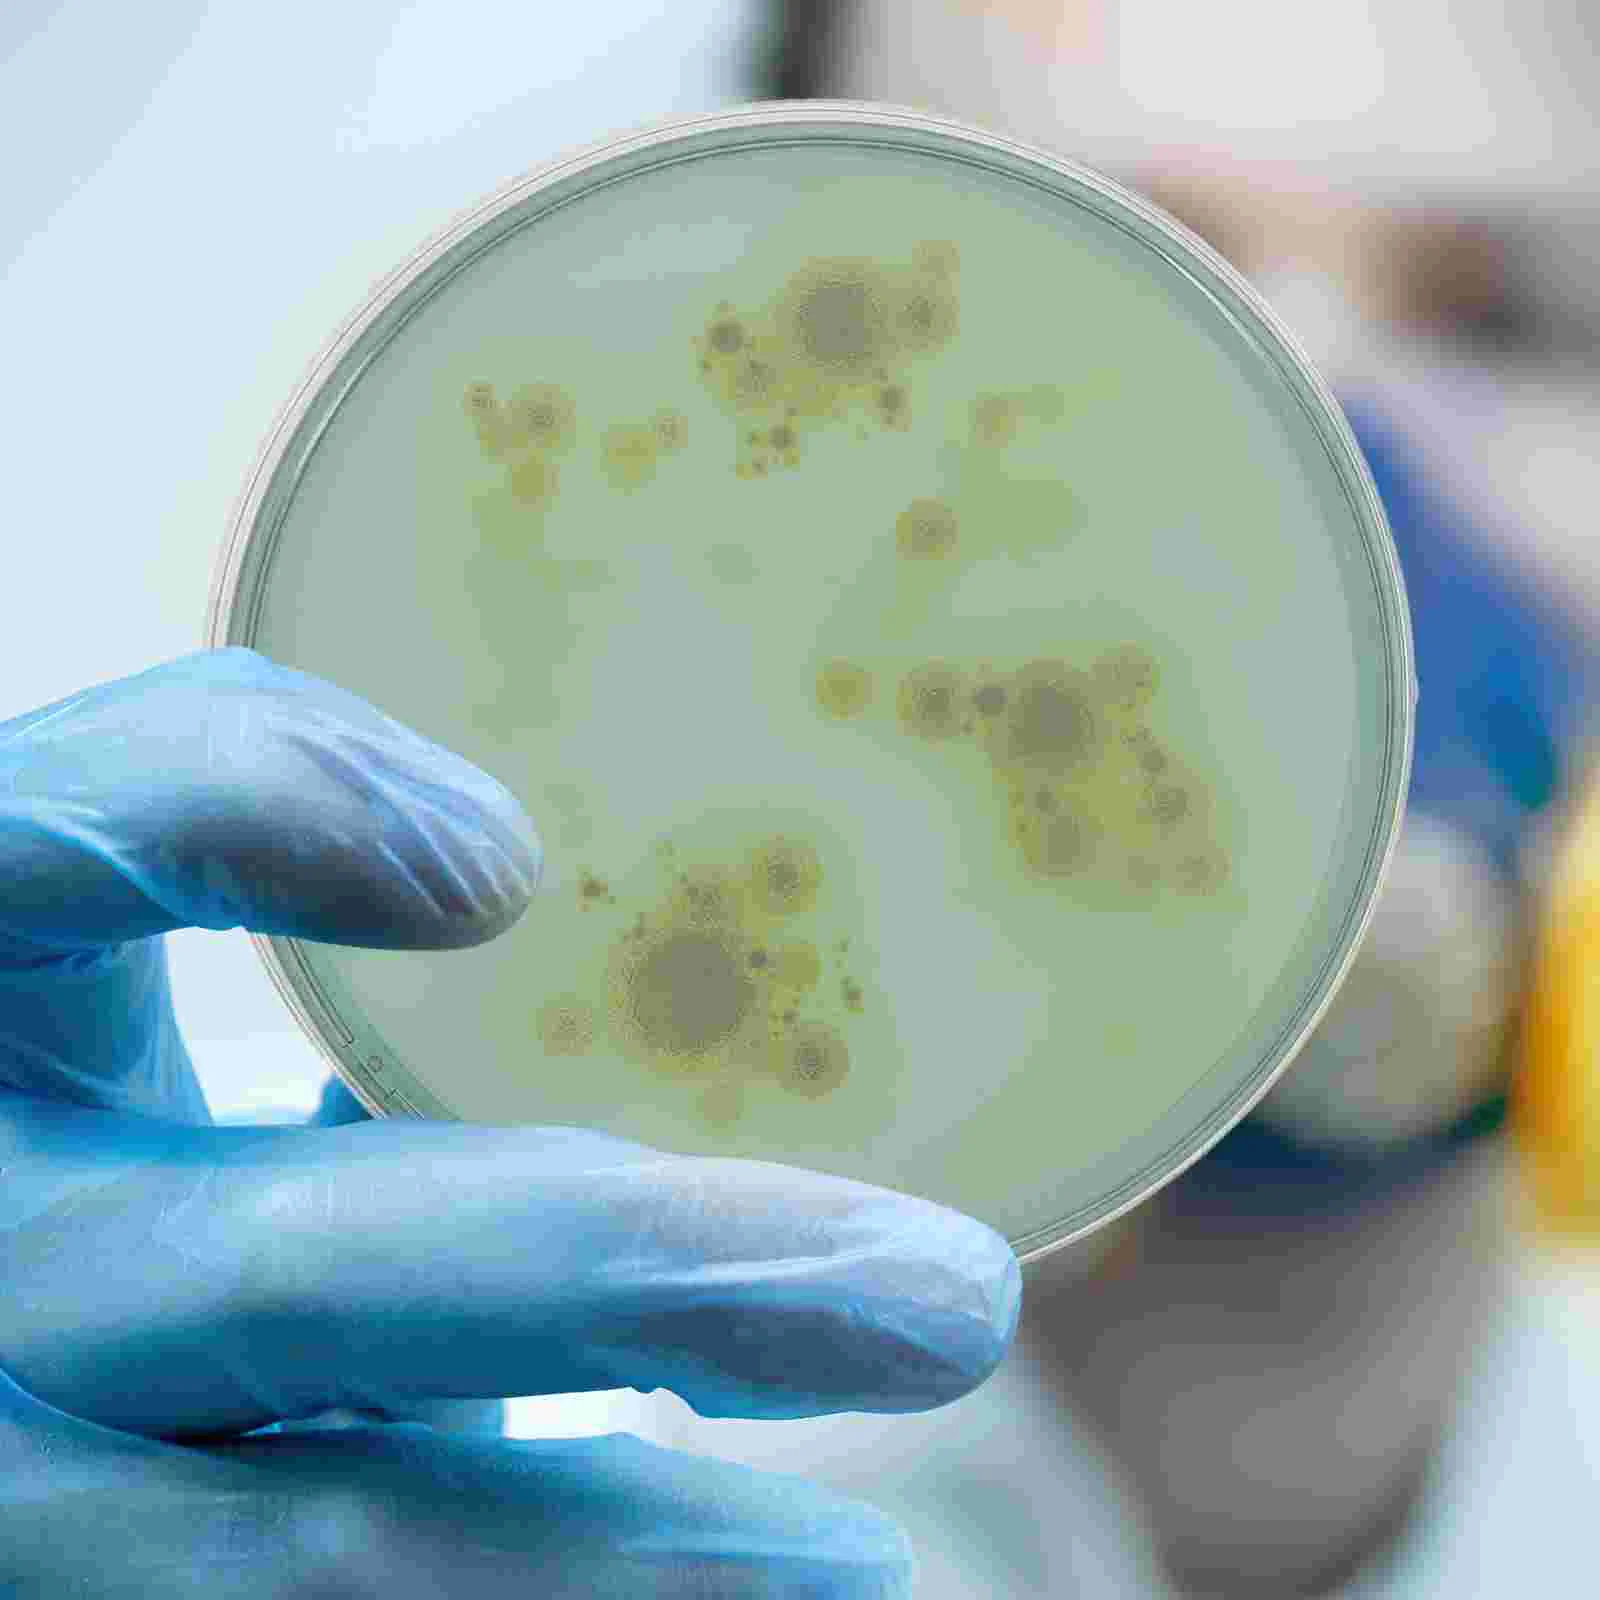

10 шт., портативные питательные Агаровые тарелки
График изменения цены & курс обмена валют
Пользователи также просматривали

$16.19
5pcs Wholesale Bendy Fashion Flexible Gold-color Chains Snake Punk Necklace 90cm*5-6mm NE0010
aliexpress.com
$91.00
Nordic Ergonomic Office Chair Glides Gaming Comfy Hoem Desk Chair Aesthetic Nordic Sillas De Oficina Interior Decoration
aliexpress.com
$9.56
Krazy Kat And Ignatz Mouse - A Love Story Knitted Cap Rave Anime Mountaineering Mens Tennis Women's
aliexpress.com
$10.57
April 18 Jim Jefferies Tank Top men clothing Men's summer clothes 2024 summer clothes for men
aliexpress.com
$9.25
8/10/16/20pcs Mini Plastic Gold Reward Trophy Cup Soccer Medals Prize Cup Early Educational Toys Football Gifts
aliexpress.ru
$12.39
Водонепроницаемое Зарядное устройство USB для мотоцикла, адаптер для быстрой зарядки в автомобиле с цифровым дисплеем и выключателем питания
aliexpress.ru
$61.55
Детектор электромагнитного излучения Дозиметр Измерители ЭДСРадиоактивный инструмент Компьютер
aliexpress.ru
$318.74
Женское Плиссированное бальное платье с открытыми плечами, зеленое платье с блестками и бисером, праздничное платье с иллюзией, 15 лет
aliexpress.ru
$0.27
Игрушка с медленным отскоком, цветной мини-торт, TPR, супер мягкий, с медленным ароматом, декомпрессионное отверстие, креативный подарок, влажный мягкий
aliexpress.ru
$0.87
Подвески для ожерелья, аксессуары для изготовления ювелирных изделий своими руками, очаровательные христианские принадлежности
aliexpress.ru
$1.84
1 шт. аниме Sanrio, фигурка, браслет, ожерелье, сплав, бейдж, мультяшный кулон, веревка, ожерелье, браслет для женщин, ювелирные изделия, подарок
aliexpress.ru
$8.31
Противоугонный замок 110 дБ, замок с сигнализацией для мотоцикла, электровелосипеда, уличный дверной замок, водонепроницаемый Противоугонный и Противоугонный
aliexpress.ru
$15.99
2023 VONDA элегантное женское платье макси на одно плечо, летний Однотонный сарафан с косым воротником, асимметричное длинное платье с оборками для женщин
aliexpress.ru
$24.02
Умный таймер управления Wi-Fi/водяным клапаном Tuya Smart Life, автоматический переключатель через Alexa Smartthings, домашний помощник Яндекс-станции 2 Alice
aliexpress.ru
$23.81
Портативный складной двойной гамак, подвесная койка для кемпинга, Путешествий, Походов, отдыха на открытом воздухе
aliexpress.ru
$7.85
Насадка для угловой шлифовальной машины 9523B, насадка для угловой шлифовальной машины, алюминиевая насадка 9913, угловая шлифовальная машина, алюминиевый корпус, аксессуары для электроинструмента
aliexpress.ru
$15.00
Беспроводная тату-машинка без аккумулятора, Вращающаяся ручка, адаптер RCA, доставка в Бразилию
aliexpress.ru
$12.52
Copper Gold Plated Necklace Earrings Jewelry Set for Women African Dubai Stud Earrings and Necklace Party Accessories Engagement
aliexpress.ru
$16.96
Кроссовки Toca Life мужские/женские, спортивная обувь на заказ, мультяшная игра, модные кроссовки для подростков, изготовленные по индивидуальному заказу, обувь для пар
aliexpress.ru
$5.75
10 Pcs Hanging Label Holder White Clip Commodity Supermarket Display Stand Pvc Pantry Organization Labels
aliexpress.ru
$8.25
Topson Double Gear Oil Nozzle Grease Tool Coupler Self-locking Lock Clamp Type High Pressure Oil Nozzle Leak-Free Grease Tip
aliexpress.ru
$210.00
Free Shipping Giant Gold/Red/Green Inflatable Christmas Ornaments Ball,Inflatable PVC Mirror Ball
aliexpress.com
$15.53
For Infinx Hot 8 Hot8 Lite X650 X650C X650B X650D LCD Replacement Mobile Phone Display Touch Digitizer Screen Assembly
aliexpress.com
$14.97
TingYiLi Sexy Front Slit Satin Ruffle Skirts Womens Summer High Waist Midi Pencil Skirt Elegant Office Ladies Black Green Skirt
aliexpress.com
$145.87
Универсальный карбюраторный воздушный фильтр 22 мм для 110cc 125cc CRF SSR Sunl Taotao Pit Bike ATV
joom.ru
$1.15
1 шт. зеленые/коричневые уплотнительные кольца FKM диаметром 5,7 мм, уплотнительные кольца из фторкаучука, прокладки OD 28-200 мм, уплотнительное к...
aliexpress.ru
$2.65
Чехол для автомобильного ремня безопасности для Geely Emgrand Ec7 Emgrand 7 Ec8 X7 EC7 GC7 SC7Pure Cotton Accessories Car-Styling 2 шт./лот
aliexpress.ru